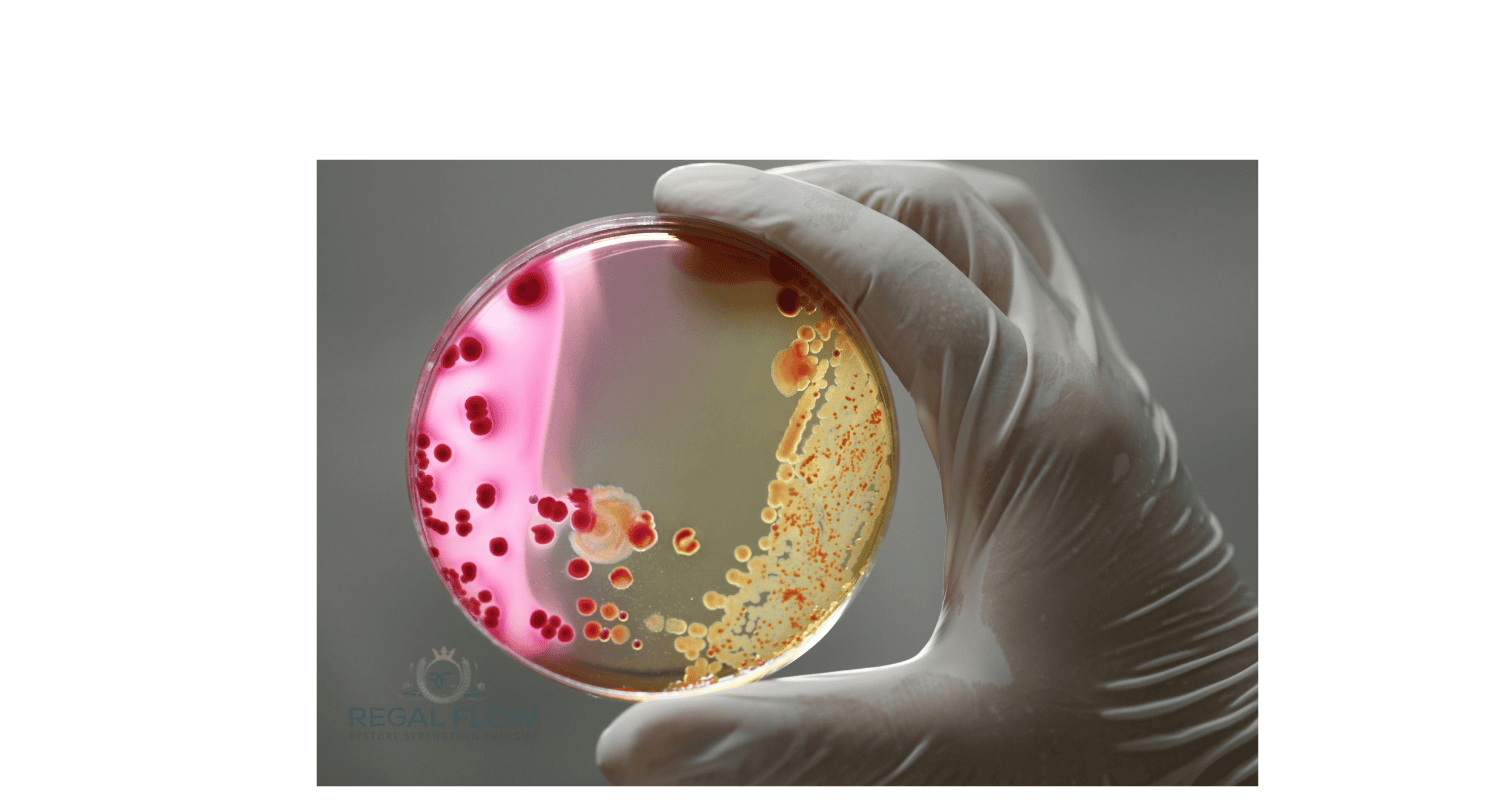
Bacteria being held in a hand

Can Reverse Osmosis Remove Bacteria? A Clear Answer for Safer Drinking Water
Ever wondered how effective a countertop dispenser with reverse osmosis really is at dealing with bacteria? While RO membranes can physically remove most bacteria, they don’t kill them outright. This article explains how bacteria are filtered, where limitations exist, and what additional steps can improve water safety. Read on for the practical details, then explore Reverse Osmosis: Specialised Topics and Advanced Insights for deeper technical insight and best-practice guidance.
Understanding Bacteria in Water
Common Types of Waterborne Bacteria
Picture this: you pour a glass of water, expecting something crisp and refreshing — but what you don’t see could spoil your day. The most common troublemakers in our water include E. coli, Salmonella, Coliform bacteria, and Legionella. These bacteria can sneak into taps through cracked pipes, old plumbing, or untreated wells. Even treated water can have issues if there’s been a blip in the supply chain. No need to panic — but it helps to know who’s gate-crashing your glass.
Health Risks Associated with Bacterial Contamination
You wouldn’t invite bacteria to dinner, and you certainly don’t want them in your tea.
At best, these microbes cause a dodgy stomach or mild diarrhoea. At worst, they can trigger gastroenteritis, typhoid, or even Legionnaires’ disease. If you’ve got children, elderly relatives or anyone with a weaker immune system at home, it’s doubly important to stay alert. Safe water isn’t just a luxury, it is a peace of mind.
How Reverse Osmosis Works as a Filtration Barrier
The Principle of the Semi-Permeable Membrane
Let’s break down how reverse osmosis (RO) keeps your water squeaky clean. Imagine it like a super-fussy colander. Water is pushed through a semi-permeable membrane under pressure so only tiny water molecules get through, leaving nasties like bacteria and viruses behind. It’s a bit like bouncers at a club door. If you’re too big (or suspicious), you’re not getting in. Simple, but seriously effective.
The Size of Bacteria Compared to RO Membrane Pores
Here’s where it gets clever. Most bacteria range from 0.2 to 2 microns in size. The pores in an RO membrane? Around 0.0001 microns. That’s like trying to squeeze a football through the eye of a needle i.e it’s not going to happen. So when bacteria come knocking, the membrane simply doesn’t let them through.
The Effectiveness of Reverse Osmosis in Removing Bacteria
Log Reduction Rates for Bacteria in RO Systems
Let’s talk numbers but don’t worry, no maths degree required.
RO systems typically achieve a 3 to 6 log reduction, which means they remove between 99.9% and 99.9999% of bacteria. In plain English? They do a cracking job. For everyday household use, that level of bacteria removal is more than enough to keep your water safe.
Factors Affecting Bacteria Removal (Membrane Integrity, Maintenance)
Now here’s the catch. An RO system won’t stay sharp if it’s neglected. If the membrane is clogged, damaged or simply past its prime, bacteria might sneak through. It’s a bit like wearing a face mask with holes in it, you wouldn’t trust it, right? Regular maintenance, like changing filters and cleaning parts, keeps your system doing its job properly.
Does RO Alone Guarantee Bacteria-Free Water?
The Importance of Pre-Filtration for Sediment Removal
Imagine trying to strain pasta through a colander that’s already clogged with gunk.
That’s what happens to an RO membrane if water is full of sediment, rust or dirt. A pre-filter removes these bigger particles first, giving the RO membrane a fighting chance.
Think of it as clearing the driveway before you mop the floor, it just makes sense. And it keeps your membrane from clogging up too soon.
The Role of Post-Filtration and Disinfection (UV, Chlorination)
Blocking bacteria is great. Killing them? Even better. This is where UV disinfection comes in. A UV system zaps any bacteria that dared to sneak through, destroying their DNA so they can’t multiply. For extra reassurance, some people add a touch of chlorination, especially if their water has a history of contamination. Used together, these methods create a solid defence system.
Comparing RO to Other Methods of Bacteria Removal
Boiling Water
Your nan was onto something with that kettle. Boiling water for 1 to 3 minutes kills most bacteria and viruses dead. It’s simple, no-nonsense and costs next to nothing. But let’s be honest, boiling every glass of water or every jug for a cuppa isn’t exactly convenient. Plus, it doesn’t filter out chemicals or metals lurking in the background.
Chlorination
Chlorination is a classic trick from the water treatment playbook. A splash of chlorine kills bacteria quickly and keeps water safe for longer storage. However, chlorine can leave behind an unwanted chemical taste. And let’s not forget, not everyone’s keen on extra chemicals swimming around in their water glass.
UV Disinfection
UV light doesn’t mess about. It blitzes bacteria and viruses by scrambling their DNA — they can’t replicate and they can’t make you sick. It’s fast, clean and chemical-free.
The downside? UV alone doesn’t remove dirt or debris, so it’s best used after filtration (like RO) for that final polish.
Conclusion: Reverse Osmosis as a Reliable Method for Bacteria Removal
So does reverse osmosis remove bacteria? Yes, and it does it brilliantly. Its membrane acts like an impenetrable barrier, keeping bacteria out of your drinking water. But to be truly confident, a smart approach is to pair it with pre-filtration (to catch sediment) and post-filtration (like UV disinfection or chlorination). Keep your RO system well maintained, and your countertop dispenser and reverse osmosis combo will pour out water so clean you’ll forget bacteria were ever a worry.
More Reverse Osmosis info we think you'll love
Reverse Osmosis Filter Replacement Service
Reverse Osmosis Power Consumption
Reverse Osmosis System Connections
Reverse Osmosis System Water Quality
When to Change Reverse Osmosis Filters
Reverse Osmosis Countertop System
Tankless Reverse Osmosis System
Reverse Osmosis Water Filter for Aquarium
How to Fix Low Water Pressure in a Reverse Osmosis System
How to Remove Air from a Reverse Osmosis System

Leave a comment